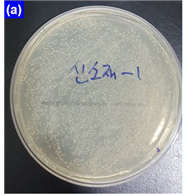

가오나시
프로젝트 개요
기술개발 과제
국문 : 스마트폰 케이스형 자외선 살균기
영문 : Smartphone case type Ultraviolet sterilizer
과제 팀명
가.오.나.시.
지도교수
홍완식 교수님
개발기간
2019년 9월 ~ 2019년 12월 (총 4개월)
구성원 소개
서울시립대학교 신소재공학부·과 2014XXX0** 이**(팀장)
서울시립대학교 신소재공학부·과 2014XXX0** 강**
서울시립대학교 신소재공학부·과 2014XXX0** 오**
서울시립대학교 신소재공학부·과 2014XXX0** 윤**
서울시립대학교 신소재공학부·과 2016XXX0** 김**
서론
개발 과제의 개요
개발 과제 요약
- 제품 소개 : 스마트폰 케이스형 자외선 살균기
- 스마트폰의 전력을 이용하여 균이 서식할 수 있는 곳(예 : 지갑, 변기, 전자제품, 유아용 제품 등)을 살균할 수 있는 스마트폰 케이스형 자외선 살균기.
- 제품의 디자인은 보조배터리 겸용 스마트폰 케이스(예 : 아이폰6s/6 배터리케이스 슈피겐 볼트팩)와 범퍼 케이스를 참고로 한다.
- 제품의 차별성
- 기존의 휴대용 자외선 살균기와는 달리 스마트폰을 통해서 전력을 공급하기 때문에 별도의 배터리 충전 혹은 건전지 교체 등의 수고스러움이 필요 없다.
- 스마트폰 케이스 형태를 표방하기 때문에 휴대가 간편하며 사용이 편리하다.
- 제품의 이미지
개발 과제의 배경
- 세균의 위험성
- 세균은 생물의 주요 분류군 중 하나로, 세포소기관을 가지지 않는 대부분의 원핵생물이 세균에 속한다. 자연계에서 무균 상태의 동식물은 없다고 추측될 정도로 지구상의 거의 모든 곳에 분포해있는 이 세균은 인체에 이로운 작용을 하기도 하지만 반대로 인체에 해로운 작용을 하기도 한다. 특히 탄저, 콜레라, 충치, 임질, 한센병, 위궤양, 흑사병, 폐렴, 결핵, 장티푸스 등의 질병에 원인이 되기도 한다.
- 일반적으로 세균이 많은 물건으로는 대표적으로 스마트폰과 마트 카트, 수도꼭지, 승강기 버튼, 카드, 리모콘, 칫솔 등이 있다. 특히 스마트폰과 칫솔의 경우 살균을 위해서 전용 살균기가 판매되고 있을 정도이다.
- 자외선 살균기의 효과
- 바이러스, 박테리아, 효모, 곰팡이와 같은 미생물은 자외선(Ultraviolet ray) 조사(照射, irradiation)를 통해 몇 초 만에 살균할 수 있다. 이는 자외선이 DNA에 흡수되어 그 구조를 파괴하고 살아있는 세포를 비활성화시키기 때문이라고 알려져 있는데, 이때 200~300nm의 파장을 가지는 자외선이 강한 살균력을 가진다.
- 자외선 살균은 이미 스마트폰 자외선 살균기, 칫솔 자외선 살균기 등에 사용되고 있는 원리이며, 휴대용 자외선 살균기 역시 시중에 판매 중이다. 하지만 이러한 제품 등을 평상시에 사용하기 위해서는 일상적으로 가지고 다니다가 필요할 때마다 꺼내어 사용해야 하는 불편함이 있다. 또한, 자외선 조사에 필요한 전력을 공급하기 위해서 배터리가 내장되어 있어 충전이 필요하거나 혹은 건전지가 필요하다.
- 시중 자외선 살균기 현황
- UV-C 기반 99.9% 살균할 수 있다.
- 제품의 크기에 따라서 AA 건전지 수 개를 사용하거나 혹은 충전 방식을 사용한다.
- 스마트폰 보급률
- 지난 2018년도 8월 26일에 송고된 매일경제 기사를 보면 국내 스마트폰 가입자 수가 5천만 명을 넘었었다. 당시 행정자치부 기준 총인구수가 5천180만 명이었던 것을 고려하면 이는 사실상, 1인당 1개의 스마트폰이 보급된 시대가 열렸다고 할 수 있다.
- 기대효과
- 일상적으로 가지고 다니는 스마트폰에 장착되는 형태로 만들어지기에 항상 휴대하기에 유리하다.
- 스마트폰의 전력을 사용하게끔 만들어 별도의 배터리가 필요 없다.
개발 과제의 목표 및 내용
- 살균기능
- 시중 휴대용 살균기 이상의 살균력, 살균 가능 거리, 필요 시간, 살균 대상 범위를 목표로 한다.
- 적용성
- 제품 장착 후에도 스마트폰의 기존 성능(스마트폰 충전 기능, NFC 태그, 냉각 기능)에 문제가 없는 디자인을 목표로 한다.
- 디자인
- 휴대가 편한 가벼운 무게와 부피를 목표로 한다.
- 본 제품과 스마트폰을 보호할 수 있을 정도의 내구성을 목표로 한다.
- 안정성
- 인체에 유해할 수 있는 UV-C 자외선을 인체에 직접 조사하는 것을 방지하는 기능을 갖는 것을 목표로 한다.
관련 기술의 현황
관련 기술의 현황 및 분석(State of art)
- State of art
1) 살균기술
(1) 살균
-살균이란 균류 등의 미생물에 자극을 가해 단시간 내에 멸살시키는 것을 뜻하며, 정도에 따라서 대상을 완전히 무균상태로 만드는 멸균과 거의 무균상태로 만드는 소독으로 구별된다. - 물리적 방법 : 가열방법은 소독할 때뿐만 아니라 특히 멸균에 이용된다. 내열성(耐熱性)의 기구(유리기구 ·도자기 ·일부금속제품 등)를 건조 상태에서 160∼180℃, 30∼60분간 가열하는 건열멸균법이 있고, 2atmHg 정도의 압력 하에서 120℃의 증기로 15∼20분간 가열하는 고압증기멸균법(오토클레이브 사용), 보통 압력 하에 100℃의 증기 속에서 1일 1회 30분 정도의 가열을 2∼3일간 되풀이하는 간헐(間歇)멸균법 등이 있다. 건조 ·일광조사 ·자외선 ·방사선 등은 소독에 이용된다. 0℃ 부근 또는 그 이하의 저온은 살균작용은 없으나 증식의 억제, 방부 등에 이용된다. - 화학적 방법 : 살균제 ·살균성가스 등이 있으며, 가열소독이 곤란한 합성수지 ·고무제품 등 외에도 사람의 손을 소독하거나 살균하는 데에 쓰인다. 역사적으로는 영국의 의사 J.리스터가 창시한 페놀산 방부법에서 비롯되었다.
(2) 자외선 살균
- 자외선은 약 397~10nm에 이르는 파장으로 이루어진 전자기파를 뜻한다. 자외선은 파장 영역에 따라 UVA (320~400nm: 선태닝, 광촉매 활성화 에너지원 등), UVB(280~320nm: 피부병 치료와 기상학 장비 등), UVC (200~280nm: 오존 파괴용, 소독용 등) 및 UVV(100~200nm: 반도체 공정에서 미량의 유기물질 제거 등) 등으로 나뉜다. - 이 중 자외선의 살균이나 화학, 생리, 형광 작용 등을 이용한 적용 분야가 확대되면서 다양한 형태의 자외선램프 가 개발되었다. 자외선램프는 겉보기에는 특별한 게 없어 보인다. 예컨대 자외선을 이용한 식기 살균기만 해도 오로지 보라 색 불빛만 보일 뿐이다. 그런데 이 불빛은 살균선에서 나오는 게 아니다. 살균램프에서 나오는 보라, 남색, 녹색, 황색 등, 색이 합성된 결과다. 살균선 자체는 결코 눈으로 볼 수 없다. 이 선을 이용해 식기나 컵 등을 살균해도 물기는 그대로 있다. 그런데 보라색 불빛의 살균력은 놀라울 정도다. 실제로 태양광선의 1600배 효과로서 표면을 3600도로 가열 한 효과와 동일하다. 이 자외선의 파장은 250nm 안팎이다. 만일 1cm2 당 100μW의 강도를 가진 자외선을 1분 간 조사하면 대장균, 디프레아균 및 이질균이 99%를 죽일 정도로 강력하다. 물론 살균 대상을 완전히 건조시키고 여러 개 겹쳐 놓지 않았을 때의 효과다. 아무리 좋은 자외선 살균기를 사용하더라도 컵에 물기가 남아 있거나 포갠 상태로 살균기에 넣으면 제대로 살균 처리가 되지 않는다. 대부분의 사람들은 자외선 살균의 효과를 일상적으로 체험한다. 좀이 슬지 않도록 햇볕에 쬐고 통풍시키는 일광 소독이 바로 그것이다. 지금까지 밝혀진 바에 따르면 자외선의 살균 작용은 조사(照射)에 의해 각종 균종의 세포 내 핵산(DAN)이 변해 신진대사에 장해를 초래하기 때문인 것으로 알려졌다. 다시 말해 박테리아나 바이러스, 효모, 곰팡이, 조류 등의 외부 세포막을 자외선이 관통하면서 세균이 생존 을 이어가고 증식하는 데 필요한 DNA를 무력화해 증식능력을 잃다가 끝내 사멸한다는 말이다. 사실 살균법에는 다양한 방식이 쓰이고 있다. 그럼에도 자외선 살균기가 일상에 널리 적용되는 이유는 자외선이 모든 균종에 대해 효과를 보이기 때문이다. 게다가 약물이나 가열, 오존 등의 처리법과 달리 피조사물에 거의 변화를 주지 않는다는 점도 자외선이 살균에 널리 쓰이는 이유이다. - 서울대 식품위생공학실 연구에 따르면 LG이노텍이 개발한 100mW UV-C LED의 경우 4℃의 온도에서 3.4초 만에 살모넬라균을 99.9% 살균하는 것으로 확인되었다.
자외선 살균기
- 시중에는 이런 자외선을 이용한 살균기 제품이 다양하게 존재한다. 칫솔용 자외선 살균기, 가정용 식기 자외선 살균기, 휴대용 살균기, 스마트폰용 자외선 살균기 등이 대표적인데, 그 중에서 칫솔용 자외선 살균기와 가정용 식기 자외선 살균기 등 설치형은 콘센트를 통해서 전력을 공급하는 방식이 주로 사용된다. 휴대용 자외선 살균기의 경우 내장 배터리 혹은 건전지를 통해서 전력을 공급하는 방식을 주로 사용하고 있으며 제품에 따라서 부피는 천차만별이나 주로 한 손으로 들고 사용하기 무리가 없는 규격을 채택하고 있다.
2) 스마트폰 케이스
스마트폰 케이스
- 스마트폰 액세서리의 일종으로 겉에 씌워 본체를 보호하고 미관을 꾸미기 위한 용도로 사용된다. 스마트폰 이전 피처폰 세대에도 드물지 않게 존재했으나 스마트폰의 경우 케이스를 씌우지 않는 경우가 드물 정도로 기본적인 액세서리로 취급받고 있다. 주로 재료 별, 형태 별로 구별된다.
- 재료에 따른 구분 : 실리콘 케이스, TPU(열가소성 폴리우레탄) 케이스, PC(폴리카보네이트) 케이스, 메탈 케이스
(1) 실리콘 케이스
스마트폰이 대중화되기 이전부터 다른 소형기기에도 많이 쓰이던 케이스인데 너무 유연하기 때문에 전면 상단과 하단베젤까지 침범해서 가리는 형식으로 이루어져 있으며 전 부위를 감싸는 만큼 핸드폰을 확실하게 보호할수 있다는 장점이 있다. 저가품은 내구도가 낮아 쉽게 헐어버리는 문제가 있지만 애플 정품 케이스같은 고가 제품은 그런 문제는 없다. 대신 먼지가 굉장히 잘 묻는 문제는 어쩔 수 없다. 재질이 매우 유연하기 때문에 얇게 만들기 곤란하여 보통 두께감이 상당하다.
(2) TPU 케이스
TPU 케이스는 탄력을 가진 부드러운 TPU 재질로 측후면을 모두 감싸는 형태로 다만 재질 특성상 너무 얇게 만들기가 곤란하기 때문에 보통 0.5mm 이상의 두께로 만들어진다. 투명 TPU를 그냥 씌우면 얼룩덜룩한 무늬가 생기는 유막 현상이 일어나서 미관상 굉장히 좋지 못한데, 이를 막기 위해 미세한 도트 패턴을 찍어 유막현상을 막는다. 실리콘 케이스보다는 뻣뻣한 편이라 측후면만 가려도 쉽게 벗겨지지 않도록 되어 있으나 반대로 탄력이 너무 없는 제품은 케이스를 끼고 벗길때 상당한 힘을 필요로 하고 이 과정에서 측면 도색이 박피되기도 한다. 케이스 안쪽에 교통카드를 넣어두는 경우도 있다. 메탈 케이스나 슬림 케이스에서는 불가능한 행동. 다만 카드를 넣으면 스마트폰의 NFC기능을 사용할 수 없다. TPU 재질로 만든 모든 투명 케이스는 청바지에서 푸른 안료가 이염될 가능성이 있고, 자외선에 오래 노출되면 서서히 노란색으로 변하는 황변 현상이 일어난다. 고급 TPU를 쓰면 황변이 늦게 일어나기는 한다지만 아예 황변을 막을수는 없다. 또한 후면 강화유리를 채택한 휴대폰에 도트패턴이 없어 유막현상이 일어나는 조악한 품질의 TPU 케이스를 오래 사용하면 유막 부분의 강화유리 코팅이 손상되어 영구적인 얼룩이 남는 경우가 많다.
(3) PC 케이스
PC 케이스는 플라스틱의 일종인 폴리카보네이트 재질로 된 얇은 케이스로, 아이폰에 씌워도 케이스 뒤로 애플 로고가 뚜렷히 비춰질 만큼 얇고 투과성이 좋은 경우가 많다. 대신 충격 보호는 기대하기 어렵고 스크래치 방지 정도의 의미만 있다.
(4) 메탈 케이스
말 그대로 금속으로 만들어진 케이스로 일반적으로 알루미늄 재질로 만든다. 극단적으로 금속만을 사용하는 케이스는 별로 없고 보통 TPU 재질 케이스에 가장자리에만 금속 범퍼를 놓는 식으로 나오는게 대부분이다.
- 형태에 따른 구분 : 범퍼 케이스, 슬림 케이스, 풀커버 케이스, 다이어리형 케이스, 뷰 커버, 거울 케이스, 배터리 케이스, 배터리 커버
(1) 범퍼 케이스
휴대폰의 측후면부를 감싸 보호하는 가장 일반적인 형태의 케이스. 측후면부만을 딱 필요한 만큼만 감싸기 때문에 풀페이스 케이스에 비해서 무게가 덜 나간다. 두께 1mm짜리 TPU 케이스만 되도 전면부나 후면부로 낙하했을 때 거의 확실한 보호를 제공해주지만 케이스가 다 그렇듯이 전면부는 막아줄 수 없기 때문에 화면 쪽으로 낙하하면 지상의 요철에 의해 크게 손상이 될 수도 있다. 측면과 더불어 후면까지 두껍게 TPU나 폴리카보네이트가 발려있는건 풀페이스 케이스라고 한다. iFace와 같은 제품들이 이에 속한다.
(2) 슬림 케이스
얇은 재질을 사용한 측후면을 덮는 케이스. 0.5~0.6mm 내외의 적당한 두께로 제품의 그립감도 살리면서 어느 정도의 보호 효과를 얻을 수 있다는 장점이 있다. 제품에 따라 폴리카보네이트를 이용한 가볍고 딱딱한 재질도 있고 TPU 등의 플렉서블한 재질도 있다. 충격흡수만 보고 1mm 이상 두께로 설계된 케이스보다 보호효과는 떨어지는 편이지만 0.5mm급 TPU 재질이라도 상당히 강한 충격도 잘 흡수할 수 있다. 하드케이스는 떨어졌을 때 휴대폰 대신 깨지거나 긁히며 충격을 흡수해준다. TPU 재질로 측면을 두르고 후면을 강화유리로 처리한 형태의 하이브리드 케이스도 있다. 강화유리를 단색으로 놓을 수도 있고 원한다면 아름다운 무늬도 넣을 수 있는 등 커스텀 범위가 넓고 후면이 유리다보니 그립감도 살릴 수 있으며 후면 도트무늬가 없어서 일반적인 케이스보다 아름답다는 장점이 있지만 문제는 방열 성능이 일반적인 TPU 재질에 비해서도 매우 떨어져서 무거운 게임을 돌릴 때 과열로 스로틀링이 심하게 걸릴 수 있고 충격보호 효과가 뛰어나기는 하지만 떨어뜨리면 휴대폰 보호하라고 끼워놓은 케이스가 박살나는 불상사가 벌어질 수 있다.
(3) 초박형 케이스
스킨 케이스라고도 한다. 보통 0.3mm의 얇은 투명 소재로 되어있어 사실상 스마트폰 디자인 그대로의 그립감을 즐길 순 있지만 너무 심하게 얇다는 태생적인 한계 탓에 그냥 책상에 내려놓거나 주머니에 넣고 뺄 때 스크래치나 안 나는 정도의 내구도만 기대할 수 있다. 낙하충격은 케이스를 안 쓸 때와 별로 다를바가 없다. 폴리카보네이트라면 케이스가 산산조각날것이고 TPU라면 사실상 휴대폰으로 충격이 그대로 전달된다. 샤오미에서 스마트폰 박스에 꼭 넣는게 이것이다.
(4) 풀커버 케이스
휴대폰의 디스플레이까지 전부 덮는 케이스. 커버형이 아니라 평소에도 덮고 있다는 점에서 다이어리형 케이스와 차별화된다. 형태는 크게 두가지인데, 아이리버 등 회사에서 만드는 투명 TPU 재질이 액정부와 후면부로 나뉘어져 액정부를 씌우고 후면부를 씌워 완전히 휴대폰을 감싸는 풀커버 젤리케이스와, 슈피겐 사에서 만드는 씬핏 360이라는 제품이 있다. 두 종류 모두 제품 특성상 휴대폰에 따로 액정보호필름을 붙일 수 없다. 투명 풀커버 케이스는 휴대폰 디자인을 그대로 보여주는데, 구조 특성상 모든 면에 대한 우수한 방호력을 자랑한다. 단점이라면 유막현상 방지를 위해 전면과 후면에 도트무늬로 인한 미관적인 부분과, 터치 감도가 비교적 떨어진다는 점이 있다. 다른 단점으로는 지문이 굉장히 많이 묻는다.
(5) 다이어리형 케이스
기본적으로 카드 수납을 전제로 하는 케이스. 젤리케이스나 일반적인 하드케이스에 추가적으로 다이어리처럼 가죽 재질 커버가 붙었고 카드 수납을 전제로 하기 때문에 카드로 인해 두꺼워진 커버가 벗겨지지 않도록 고정용 자석이 첨부되었다. 기본적으로 2~3장의 카드 수납+약간의 지폐 수납이 가능한 형태이나 아예 전면 커버를 2중 구조로 만들어서 카드를 6장 이상 수납 가능하고 지폐도 많이 넣을 수 있게 만든 경우도 있긴 있다. 너무 두껍고 커버를 젖히고 사용하기도 불편해서 청년층에는 호불호가 갈리나 중장년층에게 인기가 있는 편. 따라서 가죽으로 만든 빈티지풍의 고가 제품이 많이 팔리는 편이다.
(6) 뷰 커버
Always On Display의 대중화와 함께 큰 인기를 끈 케이스. 기본적으로 커버형이지만 덮개 일부에 구멍이 뚫려 있거나 덮개 자체가 반투명하고 덮개를 덮은 채로 터치가 가능해서 AOD 정보 확인, 통화 조작 등 일부 기능을 사용할 수 있는 케이스. 스마트폰 자체의 발전과 함께 등장하여 그냥 덮개만 달린 커버형 케이스를 도태시켜버렸다. 삼성전자의 S뷰 커버는 구멍에 아크릴이 있어서 화면보호도 겸하고 있다. 클리어뷰 커버는 전체가 투명해서 케이스를 한 채로 Always On Display를 볼 수 있다. 뷰 커버의 발전형으로. 휴대폰과 연동되어 커버를 닫으면 화면이 꺼지고 커버를 열면 화면이 켜지는 기능이 달린 케이스도 있다. LG G 시리즈에서는 퀵 커버, 아이패드 시리즈에서는 스마트 커버라고 부른다. 물론 커버와 화면 연동이라는 특성상 사실상 휴대폰 제조사에서 내놓는 정품 케이스만 가능하다고 봐도 된다. 일반적으로는 스마트폰의 지자기 센서를 이용하여 케이스 커버의 고정용 자석이 접근하면 화면을 끄는 방식이므로 각 스마트폰에 연동하여 자석 위치가 정해진 케이스에서만 작동하는데, 자석 위치는 비슷하기에 서드파티 제품도 작동한다. 안 될 경우에는 근접센서를 이용해 자동으로 온오프하는 앱을 설치해두면 간단히 비슷한 결과를 얻을 수 있다. 불투명 재질이지만 덮개에 LED가 내장되어 있어서 화면을 여닫거나 전원 버튼을 누르면 LED가 시간을 알려주는 형태의 케이스도 삼성에서 나와있다. 별도의 단자나 블루투스 기능의 활성화 없이도 휴대폰에 끼우면 자동으로 무선 연결되어 연동된다.
(7) 거울 케이스
후면이 광택이 나는 거울로 만들어진 케이스. 이 케이스를 사용하는 사람들의 입장에서 본다면 예쁜 것을 떠나서 귀찮게 거울을 따로 들고다닐 필요가 없다는 게 중요한 장점이다. 다만 케이스 자체 내구도가 큰 단점이다.
(8) 배터리 케이스
보조 배터리의 케이스 버전. 충전잭이 안쪽으로 난 타입도 있고, 무선충전을 지원하는 휴대폰 한정해서는 그냥 끼우고 케이스의 버튼을 누르면 자동으로 무선충전되는 물건도 있다. 케이스에 배터리가 달린 형태이기 때문에 당연히 일반적인 케이스에 비해 훨씬 무겁고 두껍다.
(9) 배터리 커버
휴대폰에 기본적으로 제공되는 후면 배터리 커버와 동일한 규격으로 만들어지는 대체품. 즉 휴대폰의 배터리 커버를 제거하고 대신 끼울 수 있는 일체형 케이스다. 추노마크를 피하는 선택지 중 하나. 일부 플립형 커버의 경우 후면이 배터리 커버 형식으로 되어있는 경우도 있다. 다만 최근에는 배터리 일체형으로 가는 추세라서 사라져가고 있다
- 기술 로드맵
1) 살균기술
1. 발전과정
현재에는 개인이 쉽게 들고 다닐 수 있는 규모의 휴대용 살균장치가 개발이 되어 있다.
2. 현재 기술의 문제점
① 비교적 큰 사이즈. ② 배터리를 위해 지속적인 충전이 필요. ③ 살균력이 약해 살균 시 오랜 시간이 필요.
3. 발전 방향 예측
① 휴대하기 쉽게 더 작은 사이즈로 발전. ② 살균 효과를 늘려 빠르게 살균이 가능하게 한다.
2) 휴대폰 케이스
1. 발전과정
휴대폰 케이스는 초기에는 단순히 휴대폰을 보호하는 기능만을 갖춘 장치였지만 현재는 LED, 보조배터리등 다양한 기능이 추가되어 패션아이템으로 자리 잡고 있다.
2. 현재 기술의 문제점
① 전자 부품이 달린 케이스의 경우 배터리가 들어가서 부피와 무게가 증가해야 하거나 혹은 휴대폰으로부터 지속적으로 전원을 공급받아야한다. ② 다양한 기능이 들어감에 따라 케이스의 무게가 늘어난다. ③ 커버형 케이스의 경우 케이스를 열어서 사용해야 하는 귀찮음이 존재한다.
3. 발전 방향 예측
① 휴대폰의 자기장을 이용한 자가발전. ② 가볍고 튼튼한 소재를 사용하여 무게 감소. ③ 현재 사용되는 뷰 커버 케이스를 발전시켜 휴대폰을 켜지 않고도 다양한 기능 수행.
- 특허조사
1) 살균기 관련 특허 1. 충전 기능을 구비한 휴대 단말기용 살균기 (등록번호 : 10-1597120)
요약
본 발명은 충전 기능을 구비한 휴대 단말기용 살균기에 관한 것으로, 휴대 단말기의 살균뿐만 아니라 충전이 가능하며, 소형화하여 휴대의 용이성을 향상시킨 충전 기능을 구비한 휴대 단말기용 살균기를 제공한다. 이를 위한 본 발명은 UV 광원으로 구성되고, 휴대 단말기와 대응하는 크기를 가지며, 상기 휴대 단말기를 살균하는 살균부; 상기 살균부의 동작을 개시 또는 종료하기 위한 사용자의 선택이 입력되는 조작부; 외부 전원에 의해 충전가능한 2차 전지; 외부 전원을 입력 단자부를 통하여 입력받아 상기 2차 전지의 충전 및 상기 살균부의 구동을 위한 전 압으로 변환하고, 상기 휴대 단말기를 충전하도록 상기 변환된 전원을 출력 단자부를 통하여 출력하는 전원부; 하나의 멀티 컬러 LED로 구성되고, 상기 살균부의 작동 상태 및 상기 2차 전지의 충전 상태를 표시하는 작동 표시부; 및 상기 전원부를 통하여 상기 2차 전지의 전압의 적정 여부를 판단하여 적정한 경우 상기 2차 전지의 전원을 상기 살균부의 구동 전압으로 인가하도록 제어하고, 상기 살균부의 동작 상태 및 상기 2차 전지의 충전 상태에 따라 상기 작동 표시부의 색 또는 점멸을 제어하는 제어부를 포함하는 것을 특징으로 한다.
발명의 효과
본 발명에 따른 충전 기능을 구비한 휴대 단말기용 살균기는 핸드폰, 스마트폰 등의 휴대 단말기를 효율 좋고 손쉽게 살균함으로써 유해 세균의 증식을 억제하고, 세균에 의한 2차 감염을 예방할 수 있으며, 이에 의해 세균에 의한 발병률을 낮출 수 있고, 따라서 휴대 단말기를 보다 안전하게 위생적으로 사용할 수 있는 효과가 있다. 또한, 본 발명은 간단하고 슬림한 구조에 의해 종래의 고정식 살균기에 비해 사용자 편의성을 증대하고, 접철식 차광부에 의해 실질적으로 살균을 위한 시간적 또는 공간적 제약이 없이 휴대의 편의성 및 살균의 안정성을 향상시킬 수 있다. 또한, 본 발명은 살균 기능 외에 살균 대상인 휴대 단말기의 충전 기능도 구비하여 휴대 단말기의 충전 및 보조배터리 기능을 수행함으로써 사용자에게 편의성을 증대하고, 특히, 살균과 동시에 충전이 가능함으로써 살균 또는 충전을 위한 시간을 절약할 수 있다.
2. 살균기 및 이를 포함하는 휴대용 살균 장치 (등록번호 : 10-1681750)
요약
살균기 및 이를 포함하는 휴대용 살균 장치가 개시된다. 본 발명의 일 측면에 따르면, 전원 단자가 구비되는 프레임부; 상기 프레임부에 결합되어, 상기 전원 단자를 통해 전원을 공급받아 자외선이 발생되는 LED 모듈; 및 상기 프레임부에 설치되어, 상기 전원 단자로부터 상기 프레임부의 단부로 연장되는 전도성 전원연장부를 포함하고, 상기 프레임부는 복수 개로 형성되고, 복수 개의 상기 프레임부는 상기 전도성 전원연장부 간의 접촉에 의하여 전기적으로 연결되는 것을 특징으로 하는 살균기가 제공될 수 있다.
발명의 효과
본 발명의 실시예들에 따르면, 살균 장치의 휴대 및 거치가 용이하고, 단일 전원에 복수의 LED 모듈을 연장 가능하도록 하여 살균 자외선 조사 영역의 넓이 및 방향이 조절될 수 있다.
3. 휴대단말기용 살균기 (등록번호 : 30-0856106)
디자인의 설명 1. 재질은 합성수지재 및 금속재임. 2. 본 물품은 휴대용 단말기를 살균하는 휴대단말기용 살균기를 나타낸 것임. 3. 본 물품의 전면에 형성된 커넥터에는 휴대용 단말기를 삽입하여 사용하는 것이며, 상기 커넥터를 둘러싼 타원형상의 투명렌즈 내부 공간에는 살균램프가 구비되고, 그 살균램프에서 조사되는 빛을 휴대용 단말기의 상부면을 제외한 5면에 포집되어 있는 각종 유해균을 살균하는 것임. 4. 본 물품의 후면에 형성된 충전 단자에는 충전케이블을 삽입하여 컴퓨터 또는 전원코드로 전원을 공급받을 수 있는 것임. 5. 참고도면 1.1은 사용상태를 나타낸 것으로서, 휴대용 단말기로 동영상 등을 재생시 사용자가 시청이 용이하도록 후면에 형성된 거치대가 90°로 펼쳐져 고정할 수 있는 것임.
4. 휴대용 살균기 (등록번호 : 10-1769203)
요약
본 발명은 휴대용 살균기에 관한 것이다. 본 발명에 의한 휴대용 살균기는, 상측을 향하여 UV 조사가 가능하게 배치되는 UV 램프; 상기 UV 램프에서 조사된 빛을 반사시켜 하측을 향하여 빛이 조사될 수 있도록, 상기 UV 램프와 이격된 위치에 그 UV 램프에 대해 마주하게 배치되는 반사판; 및 상기 램프와 반사판을 폐쇄시킬 수 있도록 그 램프와 반사판을 감싸는 형태로 배치되고, 상기 램프와 반사판으로부터 조사된 빛을 굴절시켜 외부로 투사되게 하는 굴절 케이스;를 포함하여 이루어져서, 본 발명이 설치되는 위치 주변의 모든 방향에서 효율적인 살균을 가능하게 한다.
발명의 효과
상술한 바와 같은 구성을 가지는 본 발명에 의한 휴대용 살균기는, 상측을 향하여 UV를 조사시키는 UV 램프와, 그 UV를 반사시켜 하측으로 향하게 하는 반사판과, UV 램프와 반사판으로부터 각각 조사되는 UV를 다양한 각도로 굴절시키는 굴절 케이스를 포함하여 이루어짐으로써, 간소한 구성을 가질 수 있게 됨에 따라 보관 및 휴대가 용이함은 물론 제조원가의 절감이 가능하게 되고, 이러한 구성에 의해서도 주변의 모든 방향에 존재하는 세균을 효과적으로 살균시킬 수 있는 장점을 도출한다.
2) 스마트폰 케이스 관련 특허 1. 보조배터리 및 유에스비 케이블을 포함하는 휴대폰 케이스 (공개번호 : 20-2017-0002571)
요약
본 고안은 휴대폰 본체가 장착되는 직사각판 형상의 케이스 본체 및 상기 케이스 본체 내부에 설치되어 일정 용량의 전원이 충전 저장되는 보조배터리를 포함하는 휴대폰 케이스에 있어서, 상기 보조배터리는 보조배터리 연결핀 및 휴대폰 연결핀이 형성된 충전핀에 의해 상기 케이스 본체에 장착된 휴대폰과 연결되고, 상기 케이스 본체 측면에는 상기 보조배터리 연결핀을 상기 케이스 본체 내부에 보관하기 위한 보조배터리 연결핀 안착홈 및 상기 휴대폰 연결핀을 상기 케이스 본체 내부에 보관하기 위한 휴대폰 연결핀 안착홈이 형성된 충전핀 안착홈이 형성되며, 상기 충전핀의 상기 휴대폰 연결핀은 휴대폰 충전부에 연결되고, 상기 보조배터리 연결핀은 상기 케이스 본체 측면에 형성된 보조배터리 연결핀 결합부에 연결되고, 상기 보조배터리 연결핀 결합부는 상기 보조배터리와 연결되어 상기 보조배터리에 저장된 전원의 출입구인 휴대폰 케이스를 제공한다. 본 고안의 휴대폰 케이스는 휴대폰 배터리 전원을 매우 손쉽게 충전할 수 있는 것은 물론, 케이스 본체 내부에 판상형의 보조 배터리를 포함하여 휴대폰과 결합 시 휴대폰 부피 증가 및 무게 증가를 최소화할 수 있는 장점이 존재한다.
고안의 효과
본 고안의 특징 및 이점을 요약하면 다음과 같다: (a) 본 고안은 휴대폰 본체가 장착되는 직사각판 형상의 케이스 본체 및 상기 케이스 본체 내부에 설치되어 일정 용량의 전원이 충전 저장되는 보조배터리를 포함하는 휴대폰 케이스에 있어서, 상기 보조배터리는 보조배터리 연결핀 및 휴대폰 연결핀이 형성된 충전핀에 의해 상기 케이스 본체에 장착된 휴대폰과 연결되고, 상기 케이스 본체 측면에는 상기 보조배터리 연결핀을 상기 케이스 본체 내부에 보관하기 위한 보조배터리 연결핀 안착홈 및 상기 휴대폰 연결핀을 상기 케이스 본체 내부에 보관하기 위한 휴대폰 연결핀 안착홈이 형성된 충전핀 안착홈이 형성되며, 상기 충전핀의 상기 휴대폰 연결핀은 휴대폰 충전부에 연결되고, 상기 보조배터리 연결핀은 상기 케이스 본체 측면에 형성된 보조배터리 연결핀 결합부에 연결되고, 상기 보조배터리 연결핀 결합부는 상기 보조배터리와 연결되어 상기 보조배터리에 저장된 전원의 출입구인 휴대폰 케이스를 제공한다. (b) 본 고안의 휴대폰 케이스는 휴대폰 배터리 전원을 매우 손쉽게 충전할 수 있는 것은 물론, 케이스 본체 내부에 판상형의 보조 배터리를 포함하여 휴대폰과 결합 시 휴대폰 부피 증가 및 무게 증가를 최소화할 수 있는 장점이 존재한다. (c) 본 고안의 휴대폰 케이스는 필요한 경우 본 고안의 케이블 안착홈에 안착된 USB 케이블을 이용하여 휴대폰 충전 또는 데이터 전송 등을 수행할 수 있는 장점이 존재한다. (d) 본 고안의 휴대폰 케이스는 1회 충전에 휴대폰 배터리 및 보조배터리 모두를 충전할 수 있는 장점이 존재한다.
2. 보조 배터리가 수납되는 휴대폰용 보호케이스 (공개번호 : 20-2016-0003706)
요약
개시된 내용은 휴대단말기용 보호케이스에 수납되는 보조 배터리의 전원을 휴대단말기에 공급하여 메인 배터리의 방전시 유용하게 활용할 수 있도록 한 것으로, 본 고안의 일 실시예에 의한 보조 배터리가 수납되는 휴대폰용 보호케이스는 휴대단말기를 감싸 보호하는 보호케이스; 상기 보호케이스의 이면에 형성되고, 보조 배터리 및 상기 보조 배터리의 전원을 상기 휴대단말기에 공급하기 위 한 연결용 잭이 수납되는 보조 배터리용 케이스; 상기 보조 배터리의 이탈을 방지하기 위해 상기 보조 배터리용 케이스에 구비되는 덮개;를 구비하는 것을 특징으로 하는 보조 배터리가 수납되는 휴대폰용 보호케이스를 제공한다.
고안의 효과
메인 배터리의 방전시 보호케이스에 수납된 보조 배터리를 보호케이스로부터 분리시키지않은 상태에서 보조 배터리의 전원을 휴대단말기에 공급하게 되므로 사용자에게 실용성을 제공할 수 있다. 또한, 보조 배터리의 전원을 휴대단말기에 공급되는 충전잭이 보호케이스의 외부로 노출되지않게 수납되므로 보호케이스가 결합된 휴대단말기를 포켓에 수납시 옷에 걸려 바닥에 떨어트리는 것을 방지할 수 있어 신뢰성을 갖게 된다. 또한, 보호케이스 및 보조 배터리를 따로 따로 구매 및 휴대가 불필요하게 되므로 경제적인 부담을 줄이고, 사용자에게 편리성 및 휴대성을 제공할 수 있다. 또한, 보호케이스의 구조 간단화로 인해 원가비용을 줄이고 외관의 슬림화 및 콤팩트화로 인해 상품성 및 구매력을 향상시킬 수 있다.
- 특허 전략
- 특허 조사 결과 휴대용 살균기 중 스마트폰 케이스 형태는 존재하지 않았다. 즉, 동일한 특허가 존재하지 않는 것을 확인했다. 또한 대부분의 휴대용 살균기 특허는 UV LED 구동을 위한 전력 공급원이 따로 필요하며 필연적으로 일정 부피 이상인 제품들이었다. 하지만 본 설계의 제품은 UV LED의 전력을 스마트폰을 통해 공급하고 스마트폰 케이스 형태로 제작하여 그러한 문제를 해결할 것이다.
- 기존 특허 중에서 스마트폰 케이스 내부에 배터리를 내장하는 기술이 존재했지만 살균기를 내장하는 기술은 존재하지 않았다. 또한 살균기 특허 중에서 얇은 살균기 모듈을 통해 다양한 구조를 만드는 기술이 존재했다. 이를 토대로 스마트폰 케이스 내부에 자외선 LED 소자 모듈을 내장시킨다는 측면에서 생각했을 때, 본 설계의 개발 과제인 ‘스마트폰 케이스형 자외선 살균기’의 실현 가능성이 충분하다고 판단했다. 또한 동일한 특허가 없으며, 기존의 특허와 형태적 요소가 차별화되어 있고, 스마트폰 케이스와 살균기 기능을 복합적으로 실현시키기 때문에 충분히 새로운 특허로써 등록이 가능하다고 판단했다.
시장상황에 대한 분석
- 경쟁제품 조사 비교
1) 휴대용 자외선 살균기 세균 zero 휴대용 자외선 살균기 세균zero는 램프 형식의 살균기로 2개의 UVC LED를 이용해 살균을 한다. 대장균, 살모넬라균 등을 대상으로 99.9% 살균이 가능하며 30분의 충전시간과 1시간 내외의 연속사용이 가능하다. 이 제품은 39g의 무게와 28ΦX94(mm)의 크기를 가졌으며 약 37,500원의 가격대로 판매되고 있다. 시중에 판매 중인 휴대용 살균기 제품 중에서는 가장 작은 편이며 가격 역시 합리적인 편이다. 하지만 이 제품 역시 외출 시 살균을 위해서 따로 휴대를 해야 한다는 불편함을 내포하고 있다. 또한 사용을 위해서는 주기적으로 따로 충전이 필요하다.
2) 휴대용 자외선 살균기 NEOST 한국전자기술(대표 전정현)은 언제 어디서나 3분이면 간편하게 살균할 수 있는 보조배터리 겸용 휴대용 UV 살균기 '네오스트(NEOST)'를 출시했다. 네오스트는 4800mAh 용량 배터리셀을 내장해 필요 시 보조배터리로 사용하고 헤드캡 체결 후 거치대와 삼각대 등 다양하게 활용 가능한 제품이다. 자체 기술을 통해 기존 자외선 살균기 단점인 특정 제품 전용을 보완해 범용성을 높였고 가격경쟁력도 뛰어나다. 또 야외에서 장시간 사용이 가능하며 99.9% 살균력이 검증된 UV-C 살균 램프 3개가 장착돼 있다. 이 제품 역시 별도의 휴대공간과 충전이 필요하다는 단점이 존재한다.
3) 케스퍼 초슬림 일체형 보조배터리 케이스 스마트폰 케이스와 보조배터리가 일체형이 제품으로 평상시에는 범퍼케이스만 사용하다가 필요할 때는 뒷면의 보조배터리 부분을 결합하여 사용하는 제품이다. 전체 두께는 17mm, 무게는 100g, 배터리 용량은 2000mAh, 연속 통화 최대 40시간이 가능한 성능을 가지고 있다. 가격대는 30000원에서 50000원 사이로 판매되며 다른 보조배터리 겸용 스마트폰 케이스 역시 이 가격대 사이에서 대부분 판매된다. 스마트폰이 일체형 배터리로 생산되는 현 추세에서 보조배터리는 스마트폰 사용자들에게 거의 필수적인 제품이 되어가고 있다. 하지만 기존의 보조배터리들은 부피가 크고 무겁거나 아니면 용량이 적은 제품들이었고 따로 휴대를 해야 하는 불편함이 있었다. 그러한 점을 보완한 제품이 이러한 보조배터리 케이스이다.
- 마케팅 전략
- 예전부터 사람들의 건강에 대한 관심은 끊이질 않아왔다. 100세 시대가 이제는 익숙해진 현대인들도 건강 문제에 대해서는 항상 촉각을 곤두세우곤 한다. 과거 메르스(MERS, 중동호흡기증후군)가 유행할 때, 손 소독제와 손 세정제 판매량이 급증했었다. 또 미세먼지 등 공기 오염의 문제가 대두됨에 따라서, 국내 공기청정기 시장이 급속도로 확대되어왔다. 이러한 점들을 보면 건강에 대한 관심에 의해서 시장이 활성화된다는 점을 알 수 있다. 살균에 대한 관심이 증가하며 살균 제품의 수요가 증가하기 시작한 것 역시 위와 같은 골자로 볼 수 있다. 이러한 작년 9월, 이미 살균 제품 수요 증가로 UV LED 기술 보유 기업인 세미콘라이트를 비롯한 일부 기업들이 스포트파이트를 받았으며, 올 4월, 조명용 LED 시장의 성장이 정체된 가운데 UV-C LED 애블리케이션이 LED시장을 견인하고 있다는 조사 결과도 존재한다.
- 작년 2018년도부터 스마트폰 가입자 수는 5천만 명을 돌파하여, 실제로 국민 거의 대부분이 스마트폰을 사용 중이라는 추산이 가능하다. 또한 스마트폰 교체 주기가 길어지면서 값비싼 스마트폰을 안전하게 보호하고, 개성까지 표현할 수 있는 스마트폰 케이스를 구매하는 소비자가 증가하는 추세이다.
- 살균에 대한 관심과 UV-C LED 시장의 증가, 높은 스마트폰 보급률과 점점 확대되는 스마트폰 케이스 시장. 이와 같은 점들을 미루어보아, 스마트폰 케이스에 살균기능을 내장시킨 ‘스마트폰 케이스형 살균기’를 스마트폰 케이스 시장과 휴대용 살균기 시장에 새로운 패러다임으로 제시할 수 있다고 판단했다.
개발과제의 기대효과
기술적 기대효과
◇ 현대인이 항상 휴대하는 스마트폰에 자외선 살균기를 결합한 형태로 항시 자외선 살균기를 휴대할 수 있다. 따라서 장소나 시간의 제약 없이 항시 살균기를 사용할 수 있다.
◇ 별도의 배터리 없이 스마트폰의 전력을 이용하기 때문에 무게가 가볍고, 스마트폰 케이스로 항상 한 손으로 휴대가 가능하다.
◇ 다양한 물건을 살균하는데 있어 기존의 휴대용 살균기보다 신속하게 사용할 수 있다.
경제적, 사회적 기대 및 파급효과
◇ 잦은 빈도로 쉽게 자외선 살균기를 이용할 수 있어 세균에 의한 다양한 문제들을 미연에 방지할 수 있다.
◇ 기존의 스마트폰 케이스에 색다르면서 필요한 기능(살균 기능)을 추가하여 새로운 스마트폰 케이스 시장을 개척할 수 있다.
◇ 살균기를 많이 사용해야하는 소비자들이(예 : 영유아의 부모들) 휴대하는 것을 잊어버릴 일 없이 어디서든 항상 살균기를 지참할 수 있게 된다.
기술개발 일정 및 추진체계
개발 일정
구성원 및 추진체계
◇ 강** : 외부 소재 선정 및 제품 디자인 설계
◇ 오** : 진행상 문제점 파악 및 해결, 시제품 제작 및 보완
◇ 윤** : 실험 수행, 자료 조사 및 개발 일정 관리
◇ 이** : 내부 회로 설계 및 시제품 성능 관리
◇ 김** : 실험 데이터 관리 및 자료 조사
설계
설계사양
제품의 요구사항
◇ 제품 요구사항의 각 항목을 D(Demand)와 W(Wish)로 나누어 분류하였다. 본 설계 제품 '스마트폰 케이스형 제외선 살균기'가 '살균기'와 '케이스'로서의 역할을 동시에 만족할 수 있는 최소한의 요구사항은 D로, 만족하지 못하더라도 '살균기'와 '케이스'로서의 역할을 수행할 수 있는 것은 W로 선정하였다.
설계 사양
개념설계안
◇ 10 : 케이스 본체 앞판
- -케이스 본체 앞판은 스마트폰을 감싸는 형태
- -스마트폰을 보호할 수 있게 충분한 내구도를 가짐
◇ 20 : 작동 스위치
- -작동 스위치를 통해 UVLED점등 및 모드 변경 가능
- -작동 스위치는 쉽게 누를 수 있는 구조 및 형태를 가짐
◇ 30 : 케이스 본체 뒷판
- -케이스 본체 뒷판은 내부 회로를 감싸는 형태
- -스마트폰을 보호할 수 있게 충분한 내구도를 가짐
- -자외선 방사에 지장이 없는 디자인
◇ 32 : 케이스 내부 회로
- -케이스 내부 회로는 PCB기판으로 제작
- -내부 회로에 장착된 UVLED가 작동하여 살균함
- -기울기 센서가 장착되어 기울기에 따라 회로를 ON/OFF시킬 수 있음
이론적 계산 및 시뮬레이션
응력 해석
- -스마트폰 낙하 시 스마트폰에 가해지는 충격량 계산
- -스마트폰 낙하시 받는 충격량 계산
- 스마트폰 + 케이스 무게 = 300g으로 으로 상정하고, 낙하 높이를 최대 2m로 가정하였을 때, 운동에너지를 계산하면 아래와 같다.
- 운동에너지 = mv2/2 = 5.88J
- v = √(2gH)
약 6배인 30N의 충격을 가했을 경우 내부 stress 시뮬레이션 결과
- ABS소재의 항복점인 44MPa을 넘지 않음
자외선 살균
- -자외선 살균량 공식
- S=P / P0 =e (-Et) / Q}
- S : 살균의 생존율
- P : 조사후의 살균수
- P0 : 조사전의 살균수
- e : 살균선의 방사강도 [㎼/㎠]
- Et : 조사시간 (min)
- Q : 생존율 S을 1 / e(36.8%)로 하는데 필요한 살균선조사량 [㎼․min]
- 계산시 99.99%의 살균을 위해서 필요한 자외선 조사량
- = 115.3mW·min/cm2
- 즉 3.82mW이상의 출력을 가진 자외선 램프로 약 30초만에 99.99퍼센트 살균이 가능함
- UV-LED의 살균력은 약 280nm에서 최대를 보임
◇자외선 살균 실험
(1) 실험 내용
- 본 설계의 목표치인 대장균 대상 99.9% 살균력을 확인하기 위해서 실험을 진행했다. 정확한 실험 결과를 위해서 ‘서울시립대학교 미생물 연구실’의 협조를 구해 실험을 진행했으며, 실험 내용은 아래와 같다.
- 일단, 대장균 배양용 영양배지를 두 개를 준비했다. 준비된 두 개의 배지에 각각 대장균을 도포한 후, 한 쪽 배지에만 자외선 살균 처리를 1분간 시행한 다음, 37℃ 3일 동안 두 배지를 인큐베이터에서 배양하여 각각의 배지에 배양된 콜로니를 관찰함으로써 진행하였다.
(2) 실험 결과
- 우측의 사진들이 3일간의 배양 후 확인된 배지의 콜로니 배양상태이다. 좌측의 (a) 배지는 자외선을 조사하지 않은 배지이고, 우측의 (b) 배지는 자외선을 조사한 배지이다. (b) 사진의 초록색 원으로 그려진 범위가 자외선의 조사범위로 그 안에는 콜로니가 배양되지 않았음을 확인할 수 있다.
상세설계 내용
조립도
- 조립도
상기 이미지는 3D 프린터를 이용해 ABS소재로 제작했으며, 아래에서부터 케이스 본체 앞판, 무선 충전 회로, 케이스 내부 회로, 케이스 본체 뒤판이다.
- 조립순서
- 케이스 본체 상판의 홈에 무선충전 모듈을 고정시킨다. 이때, 무선충전 모듈은 스마트폰의 무선배터리 공유 기능에 모듈이 인식될 수 있게끔 위치를 조정해야한다.
- 무선충전 모듈과 회로를 연결하고, 회로 역시 케이스 본체 앞판에 고정시킨다. 이때 케이스 본체 뒤판에 존재하는 열린 공간(UV 조사용)을 상정하여 회로에서 UV-C LED가 해당 열린 공간을 통해 UV를 조사할 수 있게끔 위치시킨다.
- 케이스 본체 뒤판을 케이스 본체 상판과 조립한다.
조립이 된 제품의 그림은 다음과 같다.
제어부 및 회로설계
◇전체 회로 설계사진
- -중앙의 IC칩인 Attiny85로 전체 회로를 구동
- -왼쪽 상단의 ENC-03RC 자이로 센서로 기울기를 측정
- -자외선 살균용 UV-LED 2개와 동작 확인용 LED 1개 장착
- -센서값 증폭용 신호증폭기 설치 및 로우패스/하이패스 필터 장착
◇PCB 설계 이미지
- -중앙에 UV-LED 및 작동 확인용 LED 장착
- -무선충전 모듈과 연결 가능한 터미널 단자 장착 (U5)
◇실제로 완성된 PCB기판
소프트웨어 설계
소프트웨어 작동 알고리즘
◇ 상기 소프트웨어 작동 알고리즘은 본 시제품의 회로 작동 알고리즘이다. 스마트폰의 무선 배터리 공유 기능을 통해서 회로에 전력을 공급하는 것과 작동버튼(A버튼)과 각 상황들에 맞는 작동 방식을 구현하기 위한 알고리즘을 설계했다.
(가) 상황에서는 자이로센서에 의한 작동 중지 기능이 활성화되어 60도 이상의 각도로 제품이 기울어지면 회로의 작동이 중지된다. 이는 자외선이 인체에 직접 조사되는 것을 방지하기 위한 기능이다. 이 경우에도 총 살균시간은 30초로 설정되어있으며 30초가 지나면 자동으로 회로가 정지된다.
(나) 상황은 복합적인 방향에서의 살균이 필요할 때이다. 이는 자외선의 상향 조사 혹은 측면 조사를 위해서 존재하는 기능으로 이 경우 자이로센서는 작동을 하지 않아 기울기에 따라서 회로가 정지되지 않는다. 다만 이 경우에도 30초가 지나면 자동으로 회로는 정지한다.
(다) 상황은 자외선 살균을 진행하지 않는 경우를 상정한 것이다. 살균기능의 즉각적인 정지를 원할 때를 위한 기능으로 (가) 상황 혹은 (나) 상황에서도 언제나 살균기를 바로 정지할 수 있다.
◇아두이노IDE를 이용하여 내부 펌웨어 제작
자재소요서
결과 및 평가
완료 작품의 소개
프로토타입 사진 혹은 작동 장면
◇스마트폰 케이스형 자외선 살균기 후면(좌),살균기 전면(우)
포스터
관련사업비 내역서
완료작품의 평가
향후평가
- 본 제품을 만드는 과정에서 회로의 설계부분에서 생각보다 회로의 높이가 높아져 케이스의 두께가 두꺼워졌다. 만들어진 제품의 두께는 총 18mm로 당초 예상한 20mm의 두께보다는 얇지만, 회로의 높이가 더 낮아진다면 제품의 두께를 15mm까지 줄일 수 있을 것으로 보인다. 회로의 높이가 높아진 이유는 시제품을 만들기 위해서 회로에 다양한 부품들을 결합하는 와중에 예상치 못한 문제가 발생한 것이다. 설계 중 더 향상된 성능을 위해서 본래 PCB 기판에 달고자 했던 부품보다 추가적으로 장착하여 회로가 비대해졌다. 이는 PCB기판을 다시금 설계하면 더 얇게 만들 수 있을 것이지만, 시제품을 만들 당시에는 시간 및 예산의 여유가 부족하여 따로 처리하지는 못했다. 향후 적절한 설계 수정을 통해 제작 후 평가가 이뤄져야한다.
- 본 시제품의 외형은 ABS재질로 3D 프린터로 제작되었다. 이는 추가적인 공정과 정밀한 치수 계산을 위해서는 시제품을 만들기에는 3D 프린터가 가장 적합하기 때문에 이를 사용했었다. 본 설계를 진행하면서 3D 프린터가 아닌 실리콘 몰드에 우레탄 캐스팅 기법도 감안하여 실험을 진행했었으나 3D 프린터로 제작된 케이스보다 정밀함 및 가공성이 떨어져 시제품을 만들기에는 힘들었다. 이는 정확한 캐스팅 몰드를 사용하고 공정을 준수한다면 캐스팅 등의 다른 공법으로도 제품을 만들 수 있을 것이다.
- 본 시제품에 포함된 LED는 자외선 살균용 UV-C LED와 가시광선 LED 두 종류이다. 이때 가시광선 LED의 역할은 UV-C LED의 UV 조사 범위를 가시적으로 지시해주는 것인데, 본 회로에 포함된 LED의 광량이 부족하여 실제로 선명하게 지시하지 못했다. 향후 더 선명하게 자외선 조사 범위를 지시할 수 있는 LED로 교체를 하면 문제를 해결할 수 있을 것이다.
- 현재 본 시제품은 케이스에 자외선이 조사되는 범위, UV-LED 개구부가 개방형으로 되어있다. 때문에 내부의 회로부분이 노출되어 있는데, 이를 투명 아크릴판이나 클리어 레진 등을 사용해 폐쇄하여 습기 및 외부 오염을 방지해야 한다.
- 본 제품의 설계는 스마트폰에 무선 배터리 공유기능이 있다는 전제 하에 제작되었으며 특별한 제한 조건이 없어 케이스의 크기만 맞춘다면 무선 배터리 공유기능이 있는 모든 제품에 적용이 가능하다. 또한 무선 배터리 공유기능이 없는 스마트폰도 유선으로 회로에 연결하여 전력을 공급할 수 있기 때문에 다른 c-type의 단자를 가진 스마트폰에도 충분히 적용이 가능하다고 판단된다. 이때는 케이스의 형태를 다소 변형하여 스마트폰의 충전 단자와 직접적인 결합을 할 수 있는 설계를 적용하면 된다.
특허 출원 내용
[발명의 명칭]
스마트폰 케이스 형 휴대용 자외선 살균기 (영문 : Smartphone case type Ultraviolet sterilizer)
[기술 분야]
본 발명은 스마트폰 케이스 형 휴대용 자외선 살균장치 및 그 제조방법에 관한 것으로 평상시에는 케이스 본연의 기능을 수행하다가 살균이 필요한 경우 스마트폰으로부터 전력을 공급받아 자외선을 방사하여 자외선 살균기 역할을 수행하는 방식으로 구동된다. 본 발명은 배터리등의 별도의 에너지 동력원이 필요하지 않고, 스마트폰 케이스 형태로 항시 자외선 살균기의 휴대가 가능한 것을 특징으로 한다. [발명의 배경이 되는 기술]
자외선 살균은 약 397~10nm에 이르는 파장으로 이루어진 전자기파를 이용하여 균류 등의 미생물에 자극을 가해 단시간 내에 멸살시키는 것을 뜻한다. 기존의 충전 기능을 구비한 휴대 단말기용 살균기(특허문헌001)는 자외선 살균기를 소형화하여 휴대의 용이성을 향상시켜 스마트폰 등의 휴대 단말기를 효율 좋고 손쉽게 살균함으로써 유해 세균의 증식을 억제할 수 있는 효과가 있다.
보조배터리 스마트폰 케이스는 보조배터리를 스마트폰 케이스형으로 디자인하여 케이스와 보조배터리를 결합한 형태이다. 기존의 보조배터리 및 유에스비 케이블을 포함하는 휴대폰 케이스(특허문헌002)는 상기 보조배터리는 보조배터리 연결핀 및 휴대폰 연결핀이 형성된 충전핀에 의해 상기 케이스 본체에 장착된 휴대폰과 연결되어 사용할 수 있다.
보조배터리 스마트폰 케이스 디자인에 착안하여 스마트폰 케이스형으로 자외선 살균기를 제작하고, 살균기에 각도 제한 기능을 접목시켜 자외선 살균기 사용 시 인체에 조사되는 것을 방지하고자 한다.
[선행기술문헌]
(특허문헌 001) 등록번호 : 10-1597120
(특허문헌 002) 공개번호 : 20-2017-0002571
[발명의 내용]
- [해결하고자 하는 과제]
이에 본 발명은 상기 기존 기술의 문제점들을 해결하는 것이 목적이다. 즉, 기존의 휴대용 살균기는 살균을 하기위해서는 따로 휴대해야하는 불편함이 있다. 하지만 본 발명은 개인이 소지하고 있는 휴대폰에 결합된 형태를 설계하여 휴대폰의 동력을 에너지원으로 사용 할 수 있는 휴대용 살균기를 설계하고, 살균기로 사용되는 자외선이 인체에 유해하기 때문에 최대한 인체와 접촉을 줄이도록 한 휴대용 케이스형 살균기 장치 및 제작방법을 제공하는 것이다.
- [과제의 해결수단]
본 발명의 휴대용 케이스형 살균기는 내부 회로에 UVC-LED, 작동스위치, 자이로 센서를 포함하여 구성된다.
이때, 상기 내부 회로에서 UVC-LED의 경우 강한 살균효과가 있는 280nm의 파장을 갖는 것을 사용하며, 작동스위치를 조작하여 방사방식을 조절한다. 그리고 사람을 향하거나 살균기가 뒤집어 졌을 경우 자동으로 꺼지게 만들 수 있도록 자이로 센서가 들어간다.
또한, 케이스는 핸드폰에 고정되는 옆면부, 핸드폰을 받쳐주는 후면부1, 회로를 받쳐주는 후면부2로 구성되어있다. 옆면부에는 작동 스위치가 있으며 후면부 1과2 사이에는 자외선 살균이 가능한 회로가 탑재되어있다.
본 발명의 휴대용 케이스형 살균기 제작방법은, (a) 내부회로 구성 단계, (b) 휴대용 케이스 외형 제작 단계, (c) 상기 케이스를 가공하는 단계, (d) 내부 회로 및 상기 케이스를 조립하는 단계를 포함하는 것을 특징으로 한다.
- [발명의 효과]
본 발명에 의하면, 자외선 휴대용 살균기의 동력원을 스마트 폰으로부터 공급받으므로, 다른 동력원이 설치되기 위해 필요한 공간을 절약하여 휴대성을 극대화 할 수 있다.
또한, 본 발명에 의하면, 스마트 폰을 보호하는 등의 일반적인 스마트 폰 케이스와는 다르게 자외선 살균 기능을 이용할 수 있으므로 일반적인 스마트 폰 케이스에 비해 경쟁력을 확보할 수 있다.
또한, 본 발명에 의하면, 자외선이 인체에 조사되는 것을 방지하기 위하여, 일정 기울기 이상으로 본 발명품이 기울어 질 경우, 자동으로 빛이 꺼지게 되어있으므로, 인체에 대한 안전성을 확보할 수 있다.
또한, 본 발명에 의하면, 살균 대상의 옆 또는 아랫부분을 살균하기 위하여, 일정 기울기 이상에서도 본 발명품이 작동될 수 있는 장치를 마련함으로서, 설치형 살균기 제품으로 살균하기 힘든 범위도 살균 할 수 있는 장점을 가지고 있다.
- [도면의 간단한 설명]
◇전면부 평면도(좌),후면부 평면도(우)
◇작동원리 알고리즘
◇최종 제품의 3차원 사시도(실시예)
[특허청구범위]
청구항 1
스마트폰에 장착되는 스마트폰 케이스 본체 및 내부에 자외선을 방사하는 광원이 포함되는 회로가 위치한 스마트폰 케이스; 상기의 케이스는 스마트폰으로부터 자외선 광원 구동 전력을 확보하며, 특정 조작을 통해 내부 광원을 구동시켜, 케이스 일면에서 자외선의 조사가 가능한 스마트폰 케이스.
청구항 2
제 1항에 있어서, 상기 광원을 포함한 회로는 스마트폰 케이스에 탑재되어 있고, 자외선은 스마트폰 일면부에서부터 살균대상에 국한되는 범위로 조사된다.
청구항 3
제 1항에 있어서, 스마트폰 케이스의 소재는 자외선에 변성되지 않는 소재를 사용하며, 각종 물성 및 외관을 고려하여 합성수지, 금속, 세라믹스 혹은 원목 등을 고려할 수 있다.
청구항 4
제 1항과 2항, 3항에 있어서, 스마트폰 케이스 본체 중 자외선이 외부로 조사되기 위해 투과하는 부분은 자외선 투과도가 높고 자외선에 변성되지 않는 소재를 사용하며, 유리, 세라믹스, 합성수지 등을 고려할 수 있다.
청구항 5
제 1항에 있어서, 스마트폰 케이스 내부의 광원의 구동전력은 유선 혹은 무선의 방식으로 스마트폰으로부터 공급이 가능하다.
청구항 6
제 1항에 있어서, 스마트폰과 스마트폰 케이스의 기울기에 따라서 광원이 꺼지게 할 수 있고, 특정 조작을 통해 꺼지지 않게도 할 수 있다.
청구항 7
제 1항에 있어서, 스마트폰 케이스는 무선통신, NFC 등 스마트폰이 가진 고유의 기능에 해를 끼치지 않게 한다.
청구항 8
제 1항에 있어서, 스마트폰 케이스형 자외선 살균기는 특정 조작을 통하여 (1) 광원을 구동시키고, 스마트폰과 스마트폰 케이스의 기울기에 따라서 광원의 작동이 정지될 수 있는 단계; (2) 광원을 구동시키고, 스마트폰과 스마트폰 케이스의 기울기에 따라서 광원의 작동이 정지되지 않는 단계; (3) 광원을 바로 정지시키는 단계; 상기의 단계들로 나뉜다.
청구항 9
제 8항에 있어서, (1)단계와 (2)단계는 일정 시간이 지난 후에 광원 등이 포함된 회로가 정지한다.